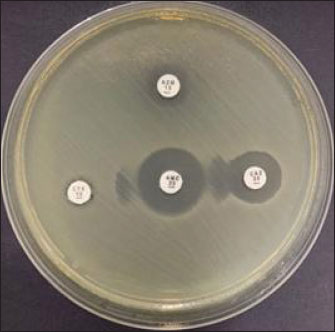

| Research Article | ||
Open Vet. J.. 2025; 15(9): 4691-4699 Open Veterinary Journal, (2025), Vol. 15(9): 4691-4699 Research Article Molecular detection of CTX-M gene from ducks sold in traditional markets in Surabaya, IndonesiaWiwiek Tyasningsih1*, Mustofa Helmi Effendi2, Aswin Rafif Khairullah3, Budiastuti Budiastuti4, Freshinta Jellia Wibisono5, Irfan Alias Kendek6, Mariana Febrilianti Resilinda7, Saifur Rehman8, Ikechukwu Benjamin Moses9 and Sheila Marty Yanestria51Division of Veterinary Microbiology, Faculty of Veterinary Medicine, Universitas Airlangga, Surabaya, Indonesia 2Division of Veterinary Public Health, Faculty of Veterinary Medicine, Universitas Airlangga, Surabaya, Indonesia 3Research Center for Veterinary Science, National Research and Innovation Agency (BRIN), Bogor, Indonesia 4Study Program of Pharmacy Science, Faculty of Health Science, Universitas Muhammadiyah Surabaya, Surabaya, Indonesia 5Department of Veterinary Public Health, Faculty of Veterinary Medicine, Universitas Wijaya Kusuma Surabaya, Surabaya, Indonesia 6Department of Microbiology, Faculty of Health, Pharmacy Study Program, Sari Mulia University, Banjarmasin, Indonesia 7Master Program in Veterinary Science and Public Health, Faculty of Veterinary Medicine, Universitas Airlangga, Surabaya, Indonesia 8Department of Pathobiology, Faculty of Veterinary and Animal Sciences, Gomal University, Dera Ismail Khan, Pakistan 9Department of Applied Microbiology, Faculty of Science, Ebonyi State University, Abakaliki, Nigeria *Corresponding Author: Wiwiek Tyasningsih. Division of Veterinary Microbiology, Faculty of Veterinary Medicine, Universitas Airlangga, Surabaya Indonesia. Email: wiwiek-t [at] fkh.unair.ac.id Submitted: 16/04/2025 Revised: 22/07/2025 Accepted: 13/08/2025 Published: 30/09/2025 © 2025 Open Veterinary Journal
AbstractBackground: Extended-spectrum β-lactamases (ESBLs), particularly those encoded by the cefotaxime (CTX-M) gene family, represent a significant threat to antimicrobial resistance. Ducks sold in traditional markets have been identified as active reservoirs of ESBL-producing bacteria, including those harboring CTX-M genes. Aim: This study aimed to molecularly detect the CTX-M gene, which encodes ESBL-producing bacteria, in ducks sold in traditional markets in Surabaya, Indonesia. Methods: A total of 144 samples were used. The isolation and identification of Escherichia coli bacteria were 83.33% (120/144) using eosin methylene blue agar media (Oxoid, England), biochemical tests, including triple sugar iron agar, Simmons citrate agar, and Indole, Methyl Red, Voges–Proskauer, and Citrate utilization tests media, such as sulfide indole motility, methyl red, and Voges–Proskauer. Isolates were positive for multidrug resistance and then subjected to the double disk synergy test. Strains that were ESBL in the double disc synergy test (DDST) test were then subjected to molecular testing of the CTX-M gene. Results: The multidrug resistant (MDR) test obtained results from 14 MDR isolates from 144 tested samples. ESBL detection was performed using the DDST, which showed that 50% (7/14) of the samples were positive for ESBL. Polymerase chain reaction test confirmation showed that 71.4% (5/7) of the samples were positive for the CTX-M gene. The resistance profile indicates high resistance to ciprofloxacin, gentamicin, and erythromycin. Conclusion: This study confirmed the presence of the CTX-M gene encoding ESBL-producing bacteria in duck cloacal swabs from traditional markets in Surabaya, highlighting the actual role of these ducks as reservoirs of antimicrobial resistance. Keywords: CTX-M, Ducks, E. coli, ESBL, Public health. IntroductionAntibiotic resistance poses a major threat to public health globally (Khairullah et al., 2022). Antibiotic resistance genes can spread between bacteria via horizontal gene transfer, and cross-resistance can result from exposure to antibiotics from distinct groups (Widodo et al., 2022). Resistance to antibiotics leads to reduced treatment efficacy, greater spread of infections, higher mortality rates, increased healthcare expenses, and challenges in the development of new antibiotics (Ramandinianto et al., 2020; Yunita et al., 2020). Transmission of antibiotic-resistant bacteria can occur directly or indirectly through wastewater, manure, soil, aerosols, pollution, and the consumption of milk, meat, and plants (Mohseni-Shahri et al., 2015; Khairullah et al., 2020; Skandalis et al., 2021). Escherichia coli is the primary bacterium that contributes to the spread of antibiotic resistance (Wardhana et al., 2021). Escherichia coli and other gram-negative bacteria belonging to the Enterobacteriaceae family produce extended-spectrum β-lactamase (ESBL) as one of their resistance mechanisms (Pradika et al., 2019). Salmonella sp. and Klebsiella pneumoniae can also produce ESBL enzymes (Wibisono et al., 2020a; Ayuti et al., 2024; Thesia et al., 2025). The β-lactamase enzyme known as spectrum β-lactamase can hydrolyze penicillin, second- and third-generation cephalosporins, and aztreonam (except cephamycin and carbapenems); however, clavulanic acid can suppress its activity (Widodo et al., 2020). ESBL-producing E. coli is a health threat and an indicator for epidemiological surveys of antibiotic resistance using a One Health approach (Wibisono et al., 2020b; Putri et al., 2024). Escherichia coli bacteria that produce ESBL can spread through a number of routes, including eating tainted meat, coming into contact with excrement in the environment, and human-to-animal transmission (Riwu et al., 2024). Contamination from poultry infected with ESBL-producing bacteria in traditional markets can result in humans being exposed to antibiotic-resistant bacteria in the market (Ahadini et al., 2025). Poor environments increase the spread of ESBL-producing E. coli, which can persist in aerosol form in the air. ESBL-producing bacteria can also be resistant to aminoglycoside antibiotics, fluoroquinolones, tetracycline, chloramphenicol, and trimethoprim-sulfamethoxazole (Widodo et al., 2023a). Previous research has shown that multidrug resistant (MDR) E. coli also produces ESBLs isolated from poultry throughout the world (Prayudi et al., 2023). The three primary genes that encode ESBL are cefotaxime (CTX-M), sulfhydryl variable (SHV), and Temoneira (a class A β-lactamase enzyme first identified in Escherichia coli) (TEM). CTX-M is transferred from a plasmid (Effendi et al., 2022). How CTX-M is distributed globally is still evolving. These genes have been detected in humans, animals, and the environment; therefore, approaches are needed to control the problem (Farizqi et al., 2023). Escherichia coli that produces ESBLs can be detected in both humans and animals that produce food, such as ducks (Uttapoln et al., 2019). It is possible that ducks harbor harmful bacteria that can infect humans and cause zoonotic illnesses. Several reports of ESBL-producing E. coli in ducks came from Thailand, amounting to 36.6% (Tansawai et al., 2019); wild ducks in Germany, 4.26% (Dreyer et al., 2022); ducks in Korea, 4.1% (Na et al., 2019); and one in 10 E. coli isolates in the Surabaya live market contained the TEM and CTX-M genes (Prayudi et al., 2023). Duck is a food product that is often consumed in Surabaya, Indonesia. The increase in duck meat consumption in Indonesia is a food safety concern. The role of ducks as reservoirs for the dissemination of AMR isolates warrants thorough investigation to establish its significance, especially for ESBL-producing isolates. Therefore, the initial step of research using cloacal swabs to ensure the presence of the CTX-M gene as the main ESBL coding gene must be performed. Identification of this issue enables the development of strategic interventions aimed at mitigating its prevalence, particularly through policies that regulate the prudent and judicious use of antibiotics in poultry farming. Materials and MethodsResearch designThis study was conducted from September 2023 to March 2024. Escherichia coli isolation and identification were conducted at the Veterinary Public Health Laboratory, Faculty of Veterinary Medicine, Wijaya Kusuma University, Surabaya. Molecular identification was conducted at the Institute of Tropical Diseases, Airlangga University, Surabaya, Indonesia. Samples were collected from five traditional market areas in Surabaya, East Java, Indonesia: West Surabaya, Central Surabaya, East Surabaya, South Surabaya, and North Surabaya. A total of 144 samples were collected from duck cloacal swabs using sterile cotton swabs (Onemed, Indonesia). Subsequently, the sample was placed in Buffered Peptone Water media (HiMedia, India) and transported to the laboratory for additional examination using a thermobox set at 4°C below. Isolation and identification of E. coli strainsDuck cloacal swab samples were cultured on eosin methylene blue agar (Oxoid, England) and then incubated at 37°C for 18–24 hours. Gram staining of bacteria is characterized by rod-shaped bacteria, which are pink in color. Biochemical tests were then performed on triple sugar iron agar (TSIA) (HIMEDIA M021), Simmons citrate agar (SCA) (HiMedia M099), and Indole, Methyl Red, Voges–Proskauer, and Citrate utilization tests media, such as SIM (HiMedia M181), methyl red (MR), and Voges–Proskauer (VP) (Merck 105712) (Effendi et al., 2022). Antibiotic sensitivity test resultsThe sensitivity test used the Kirby–Bauer method. One colony of E. coli bacteria from eosin methylene blue agar (EMBA) media was taken, mixed into a sterile physiological NaCl solution containing 8 ml in a reaction tube, and adjusted to the McFarland standard of 0.5 (1.5 × 108 CFU/ml). Next, it was cultured using a sterile cotton swab on Mueller–Hinton agar (MHA) media, and the disc was placed on MHA media. The paper disc antibiotics used in the study were aztreonam (30 µg), chloramphenicol (30 µg), gentamicin (10 µg), ciprofloxacin (5 µg), and erythromycin (15 µg). Next, it is incubated for 24 hours at 37°C. After 24 hours, the diameter of the inhibition zone can be measured using a caliper in mm according to Clinical Laboratory Standards Institute standards (CLSI, 2020), as shown in Table 1. Double disk synergy testThe isolates underwent the double disk synergy test (DDST) after testing positive for MDR. Testing was carried out on MHA media (Merck 105437) with three antibiotic discs (Oxoid, UK), including 30 µg of ceftazidime 30 µg, cefotaxime 30 µg, amoxycillin-clavulanic 30 µg, and azithromycin 30 µg, which were placed in confirmation media in parallel. A positive DDST test result showed that one of the antimicrobial drugs tested in conjunction with clavulanate had a synergistic zone with a diameter of 5 mm, which was suggestive of the antibiotic (Widodo et al., 2023a). DNA extraction and CTX-M gene detection by polymerase chain reaction (PCR)Phenotypically identified ESBL-positive E. coli isolates were examined for the presence of the CTX-M gene using a PCR. DNA extraction was performed using the QIAamp® DNA kit (QIAGEN, Germany). The purity and concentration of DNA were calculated using a spectrophotometer at wavelengths of 260 and 280 nm, respectively. The extracted DNA was stored at −20°C until further use. The PCR products were visualized by 1% agarose gel electrophoresis using UV light after staining with ethidium bromide. Positive results were indicated by the formation of a band of 550 base pairs (bp) for the CTX-M gene. A known E. coli isolate carrying the CTX-M gene (EQASIA 2021/E 21) served as the positive control, while E. coli ATCC 25922, which does not carry ESBL genes, served as the negative control. Sterile nuclease-free water was used as a no-template control in each PCR run. The CTX-M primer used forward CGC TTT GCG ATG TGC AG and reverse ACC GCG ATA TCG TTG GT genes with a length of 550 bp (Moawad et al., 2017). PCR amplification was performed with an initial denaturation at 94°C for 5 minutes, followed by 35 cycles of denaturation at 94°C for 30 seconds, annealing at 54°C for 30 seconds, and extension at 72°C for 1 minute, with a final extension at 72°C for 7 minutes. Next, 2% agarose gel electrophoresis was used to visualize the amplicons. Ethical approvalNot needed for this study. ResultsBased on the results of this study, it shows that of the 144 samples, there were 120 (83.33%) positive samples for E. coli (Table 2). The morphology of E. coli bacteria on EMBA media shows metallic green colonies, which are characteristic of lactose-fermenting bacterial colonies, and a dark center typical of lactose-fermenting colonies (Fig. 1). The results of Gram staining on E. coli bacteria are red colonies and short stems (Fig. 1). Escherichia coli bacteria were identified on TSIA, SCA, SIM, MR, and VP media (Fig. 1). The results of culture on TSIA media were characterized by a change in color from red to yellow throughout the test tube, both at the bottom (butt) and slope (slant); there was gas and negative H2S. The results of the SCA test on E. coli bacteria were negative, as indicated by the absence of a green color change on the media. The SIM test showed positive results for indole and visible motile spread of bacteria in the puncture area. Positive results for the MR test show a red color change, and the MR test for E. coli bacteria is positive (+). Voges–Proskauer test results for E. coli bacteria on VP were marked as negative. Table 1. Interpretation of inhibition zone measurements based on the provisions of CLSI (2020).
Table 2. Isolation and identification of E. coli bacteria.
Fig. 1. (A) Isolation results of E. coli bacteria on Eosin Methylene Blue Agar (EMBA); (B) Gram staining of E. coli bacteria; (C) Biochemical test results of E. coli bacteria. The results of the E. coli bacteria identification test originating from duck cloacal swabs obtained from five live market areas in Surabaya showed high results with a percentage of 83.33% (120/144). The highest percentage was in South Surabaya (100%), followed by West Surabaya (95%), Central Surabaya (87.2%), North Surabaya (78%), and East Surabaya (68.3%). The resistance pattern shows that MDR occurs for 3–4 antibiotics. The antibiotics, ciprofloxacin, gentamicin, and erythromycin, have a high resistance incidence pattern (7/14), including North Surabaya (SU10 and SU13), Central Surabaya (SP16 and SP18), East Surabaya (ST32), West Surabaya (SB14), and South Surabaya (SS15) (Table 3). The MDR test obtained results from 14 MDR isolates (Fig. 2). Furthermore, a DDST test was carried out, which showed that seven ESBL isolates originating from duck cloacal swabs at the Surabaya live market were found (Fig. 3). Overall, the incidence rate of E. coli isolates as ESBL producers from duck cloacal swabs in Surabaya was 5.83% (Table 4). The MDR test results show that live markets in the areas of North Surabaya (21.4%), South Surabaya (16.6%), East Surabaya (10.7%), Central Surabaya (9.7%), and West Surabaya (5.2%) have the highest incidence of MDR. Escherichia coli bacteria with MDR properties and E. coli as ESBL producers are 50% (7/14). Confirmation of the CTX-M gene showed positive results in 71.4% (5/7) of patients using the PCR test (Table 5). Confirmation of the ESBL-producing CTX-M gene from E. coli bacteria showed that six of the seven ESBL isolates came from the DDST test and gave rise to a positive band at 550 bp, so that 5/7 (71.4%) of the E. coli isolates had the CTX-M virulence gene (Fig. 4). DiscussionThe isolation and identification results of 144 duck cloacal swab samples at the Surabaya live market showed that 120 (83.33%) were positive for E. coli. This shows that E. coli bacteria are one of the most important members of the Enterobacteriaceae family, which are commensal and can be pathogenic in poultry (Tyasningsih et al., 2022). Normally, both pathogenic and non-pathogenic E. coli can be found on cloacal swabs (Effendi et al., 2021) Ducks themselves can be infected with E. coli bacteria in the digestive system and have a level of resistance to antibiotics. Therefore, they are isolated using agar media (Prayudi et al., 2023). Table 3. MDR patterns of antibiotic resistance.
The results of the resistance test in this study indicated that 14/120 (11.6%) patients experienced MDR. The resistance assay involved five antibiotics: aztreonam, chloramphenicol, gentamicin, ciprofloxacin, and erythromycin. The resistance assay was evaluated using a broad-spectrum class of antibiotics (Widodo et al., 2023a). Antibiotic resistance to three antibiotic classes indicates the occurrence of MDR. Prayudi et al. (2023) found that more than three to four (31.25%) varieties of antibiotics from traditional markets in Surabaya were resistant. Previous studies demonstrated that the incidence of MDR in ducks was 100% for five different antibiotic classes (Yassin et al., 2017). This demonstrates how the issue of antibiotic resistance significantly affects public health because of excrement in the marketplace (Widodo et al., 2024). Antibiotic resistance in ducks in West Bengal, India, includes gentamicin 4/47 (8.5%), chloramphenicol 2.1% 1/47 (2.1%), and ciprofloxacin 15/47 (31.91%) (Banerjee and Acharyya, 2021).
Fig. 2. Multidrug resistance profiles of E. coli isolates from duck cloacal swabs collected at five traditional markets in Surabaya, Indonesia.
Fig. 3. Double disc synergy test results for selected E. coli isolates from duck cloacal swabs collected in traditional markets in Surabaya, Indonesia. Table 4. Results of antibiotic sensitivity test, MDR, and ESBL.
The highest antibiotic resistance to erythromycin was 81.7%. The careless use of antibiotics by the poultry industry can increase the prevalence of MDR and antibiotic resistance in E. coli bacteria (Khairullah et al., 2024). Erythromycin is a macrolide antibiotic often used in the poultry industry (Wibisono et al., 2020b). The high resistance rate to erythromycin observed in our study reflects the intrinsic resistance of E. coli due to the impermeable outer membrane and active efflux mechanisms, rather than acquired resistance from antibiotic misuse (Yanestria et al., 2022). Ciprofloxacin is a broad-spectrum antibiotic frequently used in the chicken industry to treat E. coli infections in the respiratory, digestive, and urinary tracts (Ivanova et al., 2017). The results of this study were 14.2%, which was lower than that in Bangladesh (69%; Singh et al., 2012), Northern Nigeria (85%; Akanbi et al., 2022), and Egypt (26.32%; Abd El-Samie et al., 2019). These differences may reflect variations in antimicrobial usage policies, veterinary oversight, and poultry production systems. For instance, the higher prevalence of antibiotics in Bangladesh and Nigeria could be associated with the more frequent and less regulated use of antibiotics in backyard or small-scale poultry farms, as well as the limited implementation of biosecurity measures. In contrast, the relatively lower prevalence observed in the present study may be influenced by differences in farming practices, local market supply chains, and recent efforts to improve AMS in certain regions of Indonesia. Table 5. Occurrence rate of E. coli ESBL infection in MDR isolates.
Fig. 4. PCR amplification of the CTX-M gene from E. coli isolates obtained from duck cloacal swabs in traditional markets in Surabaya, Indonesia. Lane M: 100 bp DNA ladder; Lane K+: positive control; Lane K: negative control (PCR-grade water); Lanes 1–7: representative isolates tested. PCR, polymerase chain reaction. The presence of a band at approximately 544 bp indicates a positive result for the CTX-M gene. In this study, the incidence of gentamicin antibiotic resistance was 19.2%; in Bangladesh, a similar situation was also investigated in ducks, where the prevalence was 69% (Sarker et al., 2022). The results of research on resistance to the antibiotic aztreonam were 3.3%, which means that it is still sensitive. Aztreonam is rarely used in the veterinary field, but resistance to aztreonam can be transmitted through resistance genes that spread in the environment (Jorth et al., 2017). Chloramphenicol had the lowest incidence of antibiotic resistance at 2.5%. Chloramphenicol is not widely used in the veterinary world, but its resistance has been reported to exceed 50%. This is because resistance genes can change a group of bacteria to become dominantly resistant. Research on chloramphenicol antibiotic resistance has shown that 12.5% of ducks are resistant (AbdelRahman et al., 2020). Based on the research results, the phenotype test in the form of DDST was 50% (7/14) originating from five live market areas in Surabaya. Furthermore, confirmation of the CTX-M genotype test was carried out using PCR with a percentage from Central Surabaya, West Surabaya, South Surabaya, and North Surabaya of 1/1 (100%), while East Surabaya was 0/2 (0%), so that the total ESBL incidence obtained from duck cloacal swabs at the Surabaya live market was 5/7 (71.4%). The negative results from East Surabaya could be due to the presence of other β-lactamase-producing genes, such as TEM and SHV (Prayudi et al., 2023). The results of this study were lower than those that stated that the CTX-M gene was found in 15/38 (39.5%) ducks in Egypt (AbdelRahman et al., 2020) and 127/587 (27.1%) had the CTX-M gene in ducks and chickens in Thailand (Tansawai et al., 2019). However, this result was higher than what had been done in the Surabaya traditional market; namely, one in two isolates had the CTX-M gene (Putri et al., 2024). The small number of isolates subjected to molecular testing (n=7 ESBL-positive, n=5 CTX-M-positive) is a limitation of this study, which restricts the generalizability of the findings. Therefore, the results should be interpreted with caution, and further studies with larger sample sizes and broader geographic coverage are recommended to confirm these patterns. Live market conditions can spread resistance genes. This agrees with research (Widodo et al., 2023b) that ESBL-producing E. coli bacteria can be at high risk in the production of food-producing animals. Moreover, ESBL-producing E. coli has the risk of spreading resistance genes from humans to animals or vice versa, thereby posing a global threat to public health (Faridah et al., 2023). A limitation of this study is the lack of statistical comparisons between market locations due to the small number of isolates per site. As a result, the potential differences in prevalence or resistance patterns between regions could not be evaluated. Future research with a larger and more balanced sample size is needed to determine the existence of such differences. ConclusionIn conclusion, this study provides preliminary evidence of the presence of ESBL-producing and CTX-M gene-harboring E. coli in ducks sold at traditional markets in Surabaya, Indonesia. Our findings indicate ESBL-producing E. coli in ducks from live markets in Surabaya, underscoring the need for ongoing surveillance and AMS. However, given the limited sample size for molecular testing, further studies are needed to confirm these results. AcknowledgmentsThe authors would like to thank the Institute of Tropical Diseases, Airlangga University, Surabaya, for all the facilities provided during the molecular research. Conflict of interestThe authors declare no conflict of interest. FundingThis study was partly supported by the International Research Consortium, Lembaga Penelitian dan Pengabdian Masyarakat, Universitas Airlangga, Surabaya, Indonesia, Year 2024, with grant number: 171/UN3LPPM/PT.01.03/2024. Author’s contributionsWT and MHE: Conceived, designed, and coordinated the study. IAK and FJW: Designed data collection tools, supervised the field sample and data collection, and performed laboratory work and data entry. MFR and BB: Validation, supervision, and formal analysis of data. SR and SMY: Contributed reagents, materials, and analytical tools. ARK and IBM: Carried out the statistical analysis and interpretation and participated in the manuscript preparation. All authors have read, reviewed, and approved the final version of the manuscript. Data availabilityAll data are available in the revised manuscript. ReferencesAbd El-Samie, L.K., Abd-Elmoaty, A.M., Ibrahim, N.A. and Darwish, W.S. 2019. Prevealnce and molecular characterization of Avian Pathogenic Escherichia coli in Ducks. Adv. Anim. Vet. Sci. 7(S2), 163–168. AbdelRahman, M.A.A., Roshdy, H., Samir, A.H. and Hamed, E.A. 2020. Antibiotic resistance and extended-spectrum β-lactamase in Escherichia coli isolates from imported 1-day-old chicks, ducklings, and turkey poults. Vet. World 13(6), 1037–1044. Ahadini, S.N., Tyasningsih, W., Effendi, M.H., Khairullah, A.R., Kusala, M.K.J., Fauziah, I., Latifah, L., Moses, I.B., Yanestria, S.M., Fauzia, K.A., Kurniasih, D.A.A. and Wibowo, S. 2025. Molecular detection of blaTEM-encoding genes in multidrug-resistant Escherichia coli from cloacal swabs of ducks in Indonesia farms. Open Vet. J. 15(1), 92–97. Akanbi, O.B., Olorunshola, I.D., Osilojo, P., Ademola, E., Agada, G., Aiyedun, J., Odita, C.I. and Ola-Fadunsin, S.D. 2022. Escherichia coli infections, and antimicrobial resistance in poultry flocks, in North Central Nigeria. Vet. Med. J. 33(3), 188–207. Ayuti, S.R., Khairullah, A.R., Al-Arif, M.A., Lamid, M., Warsito, S.H., Moses, I.B., Hermawan, I.P., Silaen, O.S.M., Lokapirnasari, W.P., Aryaloka, S., Ferasyi, T.R., Hasib, A. and Delima, M. 2024. Tackling salmonellosis: a comprehensive exploration of risks factors, impacts, and solutions. Open Vet. J. 14(6), 1313–1329. Banerjee, A. and Acharyya, S. 2021. Prevalence of antibiotic resistance genes in indian ducks: a comparative study between Deshi And Khaki Campbell Ducks. Explor. Anim. Med. Res. 11(1), 30–37. CLSI (Clinical and Laboratory Standards Institute). 2020. Performance Standards for Antimicrobial Disk Diffusion Susceptibility Testing; 17th Informational Supplement. Approved Standard M100-17. Wyne, PA: Clinical and Laboratory Standards Institute. Dreyer, S., Globig, A., Bachmann, L., Schütz, A.K., Schaufler, K. and Homeier-Bachmann, T. 2022. Longitudinal study on extended-spectrum beta-lactamase-E. coli in sentinel mallard ducks in an important baltic stop-over site for migratory ducks in Germany. Microorganisms 10(10), 1968. Effendi, M.H., Hartadi, E.B., Witaningrum, A.M., Permatasari, D.A. and Ugbo, E.N. 2022. Molecular identification of blaTEM gene of extended-spectrum beta-lactamase-producing Escherichia coli from healthy pigs in Malang district, East Java, Indonesia. J. Adv. Vet. Anim. Res. 9(3), 447–452. Effendi, M.H., Tyasningsih, W., Yurianti, Y.A., Rahmahani, J., Harijani, N. and Plumeriastuti, H. 2021. Presence of multidrug resistance (MDR) and extended-spectrum beta-lactamase (ESBL) of Escherichia coli isolated from cloacal swabs of broilers in several wet markets in Surabaya, Indonesia. Biodiversitas 22(1), 304–310. Faridah, H.D., Wibisono, F.M., Wibisono, F.J., Nisa, N., Fatimah, F., Effendi, M.H., Ugbo, E.N., Khairullah, A.R., Kurniawan, S.C. and Silaen, O.S.M. 2023. Prevalence of the blaCTX-M and blaTEM genes among extended-spectrum beta lactamase-producing Escherichia coli isolated from broiler chickens in Indonesia. J. Vet. Res. 67(2), 179–186. Farizqi, M.T.I., Effendi, M.H., Adikara, R.T.S., Yudaniayanti, I.S., Putra, G.D.S., Khairullah, A.R., Kurniawan, S.C., Silaen, O.S.M., Ramadhani, S., Millannia, S.K., Kaben, S.E. and Waruwu, Y.K.K. 2023. Detection of extended-spectrum β-lactamase-producing Escherichia coli genes isolated from cat rectal swabs at Surabaya Veterinary Hospital, Indonesia, Vet. World 16(9), 1917–1925. Ivanova, S., Dimitrova, D.J. and Petrichev, M. 2017. Pharmacokinetics of ciprofloxacin in broiler chickens after single intravenous and intraingluvial administration. Maced. Vet. Rev. 40(1), 67–72. Jorth, P., McLean, K., Ratjen, A., Secor, P.R., Bautista, G.E., Ravishankar, S., Rezayat, A., Garudathri, J., Harrison, J.J., Harwood, R.A., Penewit, K., Waalkes, A., Singh, P.K. and Salipante, S.J. 2017. Evolved aztreonam resistance is multifactorial and can produce hypervirulence in Pseudomonas aeruginosa. mBio 8(5), e00517–17. Khairullah, A.R., Afnani, D.A., Riwu, K.H.P., Widodo, A., Yanestria, S.M., Moses, I.B., Effendi, M.H., Ramandinianto, S.C., Wibowo, S., Fauziah, I., Kusala, M.K.J., Fauzia, K.A., Furqoni, A.H. and Raissa, R. 2024. Avian pathogenic Escherichia coli: Epidemiology, virulence and pathogenesis, diagnosis, pathophysiology, transmission, vaccination, and control. Vet. World 17(12), 2747–2762. Khairullah A.R., Ramandinianto S.C. and Effendi M.H., 2020. A review of livestock-associated methicillin-resistant Staphylococcus aureus (LA-MRSA) on bovine mastitis. Syst. Rev. Pharm. 11, 172–183. Khairullah, A.R., Rehman, S., Sudjarwo, S.A., Effendi, M.H., Ramandinianto, S.C., Gololodo, M.A., Widodo, A., Riwu, K.H.P. and Kurniawati, D.A. 2022. Detection of mecA gene and methicillin-resistant Staphylococcus aureus (MRSA) isolated from milk and risk factors from farms in Probolinggo, Indonesia. F1000Res. 11(1), 722. Moawad, A.A., Hotzel, H., Awad, O., Tomaso, H., Neubauer, H., Hafez, H.M. and El-Adawy, H. 2017. Occurrence of Salmonella enterica and Escherichia coli in raw chicken and beef meat in northern Egypt and dissemination of their antibiotic resistance markers. Gut Pathog. 9(1), 57. Mohseni-Shahri, F.S., Housaindokht, M.R., Bozorgmehr, M.R. and Moosavi-Movahedi, A.A. 2015. Studies of interaction between propranolol and human serum albumin in the presence of DMMP by molecular spectroscopy and molecular dynamics simulation. Biomacromolecular J. 1(2), 154–166. Na, S.H., Moon, D.C., Choi, M.J., Oh, S.J., Jung, D.Y., Sung, E.J., Kang, H.Y., Hyun, B.H. and Lim, S.K. 2019. Antimicrobial resistance and molecular characterization of extended-spectrum β-lactamase-producing Escherichia coli isolated from ducks in South Korea. Foodborne Pathog. Dis. 16(12), 799–806. Pradika, A.Y., Chusniati, S., Purnama, M.T.E., Effendi, M.H., Yudhana, A. and Wibawati, P.A. 2019. Total test of Escherichia coli on fresh cow milk at dairy farmer cooperative (KPSP) Karyo Ngremboko Purwoharjo Banyuwangi. J. Med. Vet. 2(1), 1–6. Prayudi, S.K.A., Effendi, M.H., Lukiswanto, B.S., Az Zahra, R.L., Benjamin, M.I., Kurniawan, S.C., Khairullah, A.R., Silaen, O.S.M., Lisnanti, E.F., Baihaqi, Z.A., Widodo, A. and Riwu, K.H.P. 2023. Detection of genes on Eschericia coli producing extended spectrum β-lactamase isolated from the small intestine of ducks in traditional markets Surabaya City, Indonesia. J. Adv. Vet. Res. 13(8), 1600–1608. Putri, M.F.R., Khairullah, A.R., Effendi, M.H., Wibisono, F.J., Hasib, A., Moses, I.B., Fauziah, I., Kusala, M.K.J., Raissa, R. and Yanestria, S.M. 2024. Detection of the CTX-M Gene associated with extended-spectrum β-lactamase (ESBL) in broiler chickens in Surabaya traditional markets. J. Med. Vet. 7(2), 320–334. Ramandinianto, S.C., Khairullah, A.R., Effendi, M.H. and Hestiana, E.P. 2020. Profile of multidrug resistance (MDR) and methicillin resistant Staphylococcus aureus (MRSA) on dairy farms in east Java province, Indonesia. Indian J. Forensic Med. Toxicol. 14(4), 3439–3445. Riwu, K.H.P., Effendi, M.H., Rantam, F.A., Khairullah, A.R., Kurniawan, S.C., Kurniawan, A., Moses, I.B., Hasib, A., Widodo, A., Yanestria, S.M., Silaen, O.S.M. and Shehzad, A. 2024. Molecular detection of blaTEM gene for encoding extended spectrum beta-lactamase (ESBL) on Escherichia coli isolated from deer feces in Indonesia. J. Adv. Vet. Res. 14(4), 722–726. Sarker, M.S., Kabir, M.E., Mahua, F.A., Ahmed, A., Ripon, R.K., Silva, V., Poeta, P. and Ahad, A. 2022. Antibiotic-resistant Escherichia coli isolated from duck cloacal and tap water samples at live bird markets in Bangladesh. Poult. Sci. J. 11(1), 19–27. Singh, A., Khan, M.S.R., Saha, S., Hassan, J. and Roy, U. 2012. Isolation and detection of antibiotic sensitivity pattern of Escherichia coli from ducks in Bangladesh and Nepal. Microb. Health 1(1), 6–8. Skandalis, N., Maeusli, M., Papafotis, D., Miller, S., Lee, B., Theologidis, I. and Luna, B. 2021. Environmental spread of antibiotic resistance. Antibiotics (Basel) 10(6), 640. Tansawai U., Walsh T.R. and Niumsup P.R. 2019. Extended spectrum β-lactamase-producing Escherichia coli among backyard poultry farms, farmers, and environments in Thailand. Poult. Sci. 98(6), 2622–2631. Thesia, N.L.N., Khairullah, A.R., Effendi, M.H., Tyasningsih, W., Puspitasari, Y., Ahadini, S.N., Moses, I.B., Yanestria, S.M., Riwu, K.H.P., Wasito, W., Baihaqi, Z.A. and Ahmad, R.Z. 2025. Detection of multidrug-resistant Klebsiella pneumoniae isolated from duck cloacal swab in Jombang, Indonesia. Open Vet. J. 15(1), 300–306. Tyasningsih, W., Ramandinianto, S.C., Ansharieta, R., Witaningrum, A.M., Permatasari, D.A., Wardhana, D.K., Effendi, M.H. and Ugbo, E.N. 2022. Prevalence and antibiotic resistance of Staphylococcus aureus and Escherichia coli isolated from raw milk in East Java, Indonesia. Vet. World 15(8), 2021–2028. Uttapoln, T., Timothy, R.W. and Pannika R.N. 2019. Extended spectrum β-lactamase-producing Escherichia coli among backyard poultry farms, farmers, and environments in Thailand. Poult. Sci. 98(6), 2622–2631. Wardhana, D.K., Safitri, D.A., Annisa, S., Harijani, N., Estoepangestie, A.T.S. and Maghfiroh, L. 2021. Prevalence of extended-spectrum beta-lactamases in producing Escherichia coli in beef sold in traditional markets in Surabaya, Indonesia. Biodiversitas 22(5), 2789–2793. Wibisono F.J., Sumiarto B., Untari T., Effendi M.H., Permatasari D.A. and Witaningrum A.M. 2020a. CTX Gene of extended spectrum beta-lactamase (ESBL) producing Escherichia coli on broilers in Blitar, Indonesia. Syst. Rev. Pharm. 11(7), 396–403. Wibisono, F.J. Sumiarto, B, Untari, T, Effendi, M.H, Permatasari, D.A and Witaningrum. A.M. 2020b. The presence of extended-spectrum beta-lactamases (ESBL) producing Escherichia coli on layer chicken farms in Blitar Area, Indonesia. Biodiversitas 21(6), 2667–2671. Widodo, A., Effendi, M.H. and Khairullah, A.R. 2020. Extended-spectrum beta-lactamase (ESBL)-producing Eschericia coli from livestock. Syst. Rev. Pharm. 11(7), 382–392. Widodo, A., Khairullah, A.R., Effendi, M.H., Moses, I.B. and Agustin, A.L.D. 2024. Extended-spectrum β-lactamase-producing Escherichia coli from poultry: a review. Vet. World 17(9), 2017–2027. Widodo, A., Lamid, M., Effendi, M.H., Khairullah, A.R., Kurniawan, S.C., Silaen, O.S.M., Riwu, K.H.P., Yustinasari, L.R., Afnani, D.A., Dameanti, F.N.A.E.P. and Ramandinianto, S.C. 2023a. Antimicrobial resistance characteristics of multidrug resistance and extended-spectrum beta-lactamase producing Escherichia coli from several dairy farms in Probolinggo, Indonesia. Biodiversitas 24(1), 215–221. Widodo, A., Lamid, M., Effendi, M.H., Khairullah, A.R., Riwu, K.H.P., Yustinasari, L.R., Kurniawan, S.C., Ansori, A.N.M., Silaen, O.S.M. and Dameanti, F.N.A.E.P. 2022. Antibiotic sensitivity profile of multidrug-resistant (MDR) Escherichia coli isolated from dairy cow’s milk in Probolinggo, Indonesia. Biodiversitas 23(10), 4971–4976. Widodo, A., Lamid, M., Effendi, M.H., Tyasningsih, W., Raharjo, D., Khairullah, A.R., Kurniawan, S.C., Yustinasari, L.R., Riwu, K.H.P. and Silaen, O.S.M. 2023b. Molecular identification of blaTEM and blaCTX-M genes in multidrug-resistant Escherichia coli found in milk samples from dairy cattle farms in Tulungagung, Indonesia. J. Vet. Res. 67(3), 381–388. Yanestria, S.M., Dameanti, F.N.A.E.P., Musayannah, B.G., Pratama, J.W.A., Witaningrum, A.M., Effendi, M.H. and Ugbo, E.N. 2022. Antibiotic resistance pattern of extended-spectrum ?-lactamase (ESBL) producing Escherichia coli isolated from broiler farm environment in Pasuruan district, Indonesia. Biodiversitas 23(9), 4460–4465. Yassin, A.K., Gong, J., Kelly, P., Lu, G., Guardabassi, L., Wei, L., Han, X., Qiu, H., Price, S., Cheng, D. and Wang, C. 2017. Antimicrobial resistance in clinical Escherichia coli isolates from poultry and livestock, China. PLoS One 12(9), e0185326. Yunita, M.N., Effendi, M.H., Rahmaniar, R.P., Arifah, S. and Yanestria, S.M. 2020. Identification of spa gene for strain typing of methicillin resistant Staphylococcus aureus (MRSA) isolated from nasal swab of dogs. Biochem. Cell. Arch. 20(1), 2999–3004. | ||
| How to Cite this Article |
| Pubmed Style Tyasningsih W, Effendi MH, Khairullah AR, Budiastuti B, Wibisono FJ, Kendek IA, Resilinda MF, Rehman S, Moses IB, Yanestria SM. Molecular detection of CTX-M gene from ducks sold in traditional markets in Surabaya, Indonesia. Open Vet. J.. 2025; 15(9): 4691-4699. doi:10.5455/OVJ.2025.v15.i9.73 Web Style Tyasningsih W, Effendi MH, Khairullah AR, Budiastuti B, Wibisono FJ, Kendek IA, Resilinda MF, Rehman S, Moses IB, Yanestria SM. Molecular detection of CTX-M gene from ducks sold in traditional markets in Surabaya, Indonesia. https://www.openveterinaryjournal.com/?mno=252900 [Access: January 25, 2026]. doi:10.5455/OVJ.2025.v15.i9.73 AMA (American Medical Association) Style Tyasningsih W, Effendi MH, Khairullah AR, Budiastuti B, Wibisono FJ, Kendek IA, Resilinda MF, Rehman S, Moses IB, Yanestria SM. Molecular detection of CTX-M gene from ducks sold in traditional markets in Surabaya, Indonesia. Open Vet. J.. 2025; 15(9): 4691-4699. doi:10.5455/OVJ.2025.v15.i9.73 Vancouver/ICMJE Style Tyasningsih W, Effendi MH, Khairullah AR, Budiastuti B, Wibisono FJ, Kendek IA, Resilinda MF, Rehman S, Moses IB, Yanestria SM. Molecular detection of CTX-M gene from ducks sold in traditional markets in Surabaya, Indonesia. Open Vet. J.. (2025), [cited January 25, 2026]; 15(9): 4691-4699. doi:10.5455/OVJ.2025.v15.i9.73 Harvard Style Tyasningsih, W., Effendi, . M. H., Khairullah, . A. R., Budiastuti, . B., Wibisono, . F. J., Kendek, . I. A., Resilinda, . M. F., Rehman, . S., Moses, . I. B. & Yanestria, . S. M. (2025) Molecular detection of CTX-M gene from ducks sold in traditional markets in Surabaya, Indonesia. Open Vet. J., 15 (9), 4691-4699. doi:10.5455/OVJ.2025.v15.i9.73 Turabian Style Tyasningsih, Wiwiek, Mustofa Helmi Effendi, Aswin Rafif Khairullah, Budiastuti Budiastuti, Freshinta Jellia Wibisono, Irfan Alias Kendek, Mariana Febrilianti Resilinda, Saifur Rehman, Ikechukwu Benjamin Moses, and Sheila Marty Yanestria. 2025. Molecular detection of CTX-M gene from ducks sold in traditional markets in Surabaya, Indonesia. Open Veterinary Journal, 15 (9), 4691-4699. doi:10.5455/OVJ.2025.v15.i9.73 Chicago Style Tyasningsih, Wiwiek, Mustofa Helmi Effendi, Aswin Rafif Khairullah, Budiastuti Budiastuti, Freshinta Jellia Wibisono, Irfan Alias Kendek, Mariana Febrilianti Resilinda, Saifur Rehman, Ikechukwu Benjamin Moses, and Sheila Marty Yanestria. "Molecular detection of CTX-M gene from ducks sold in traditional markets in Surabaya, Indonesia." Open Veterinary Journal 15 (2025), 4691-4699. doi:10.5455/OVJ.2025.v15.i9.73 MLA (The Modern Language Association) Style Tyasningsih, Wiwiek, Mustofa Helmi Effendi, Aswin Rafif Khairullah, Budiastuti Budiastuti, Freshinta Jellia Wibisono, Irfan Alias Kendek, Mariana Febrilianti Resilinda, Saifur Rehman, Ikechukwu Benjamin Moses, and Sheila Marty Yanestria. "Molecular detection of CTX-M gene from ducks sold in traditional markets in Surabaya, Indonesia." Open Veterinary Journal 15.9 (2025), 4691-4699. Print. doi:10.5455/OVJ.2025.v15.i9.73 APA (American Psychological Association) Style Tyasningsih, W., Effendi, . M. H., Khairullah, . A. R., Budiastuti, . B., Wibisono, . F. J., Kendek, . I. A., Resilinda, . M. F., Rehman, . S., Moses, . I. B. & Yanestria, . S. M. (2025) Molecular detection of CTX-M gene from ducks sold in traditional markets in Surabaya, Indonesia. Open Veterinary Journal, 15 (9), 4691-4699. doi:10.5455/OVJ.2025.v15.i9.73 |